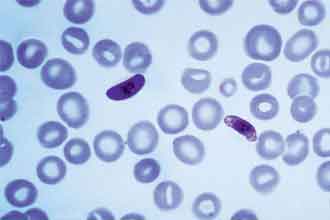
informat_1551318335160

号称能治愈癌症的方法并不少见,比如近日刷屏的疟原虫治癌法。
中科院广州生物医药与健康研究院教授陈小平在一次演讲中公布了一个重磅消息——疟原虫可成为抗癌生力军,通过让人感染疟原虫来治愈晚期癌症。然而这却被业内专家提出其结果是不可轻信的。
但是仍然有很多癌症患者及其亲属相信陈小平。但如果治疗令人谈之色变的癌症时,把可能说成一定,把治疗说成完全治愈,把个别案例的现状说成一个群体病例性的突破成功,就有违科学研究的本意了。这不仅歪曲了事实,引发了争执,也让一些正处于绝望中的癌症病人对这种尚未成熟的疗法产生了盲目的迷信。
2月14日,疟原虫免疫疗法临床研究项目组宣布临床研究招募志愿者名额已满。有媒体记录了报名的火爆:百余人汇集到相关医院填写报名表。据报道,在消息传出后,有两万多名癌症患者蜂拥而去,请求报名加入陈小平的“疟原虫治疗癌症”试验。
有一个癌症患者家属说:我父亲已是癌症晚期,没有很好的治疗方法,我们这是“死马当活马医”,不管有没有效都要试一试。
正是很多癌症晚期患者及其家属抱着这种“死马当活马医”的心态,让再荒唐的、再不可靠的治疗癌症方法,都能被推销出去。
应重视癌症晚期病人的生活质量。癌症晚期的病人即使已经没有了可以治好的希望,也还可以接受规范的治疗来缓解痛苦,提高生活质量。如果要去尝试效果不明的新疗法,也应该选择那些已知比较安全的疗法,以免对身体造成进一步的伤害,带来新的痛苦。
医学伦理有一条公认的原则,叫做“不伤害原则”,又叫“无伤原则”,就是要求首先考虑到和最大限度地降低对病人或研究对象的伤害。这源于西方医学之父希波克拉底的教导:医生在治疗疾病时,要慎重做出选择,要么对病人有益,要么不对病人造成伤害。如果一种治疗,其害处的确定性大于好处的确定性,那么宁愿不做治疗,以免对病人造成伤害。
医学的这种特殊性质也决定着应该不伤害病人或研究对象,最大限度地降低对病人或研究对象的伤害。在生物医学中“伤害”主要指身体上的伤害,包括疼痛和痛苦、残疾和死亡,以及精神上的伤害和其他损害,如经济上的损失。
目前来看,“疟原虫治疗癌症”不是一种安全的疗法,已知会对患者造成重大伤害。它是要让患者感染疟原虫诱发疟疾,而疟疾是一种非常凶险的疾病,让患者感到痛苦,甚至致命,而且具有很强的传染性。就“疟原虫治疗癌症”的试验而言,它对病人的害处是明显而且确定的,而对病人的好处是不明显、不确定的,在这种情况下,根据“不伤害原则”,就不应该做治疗。
从科学的角度去分析,让疟原虫成为一个能够真正治愈癌症的“神药”,还有很长的路要走。科学家应该对科学技术成果怀揣憧憬的同时,对生命科学事业也应保持敬畏,别让盲目自信成为科学发展道路上的绊脚石。
